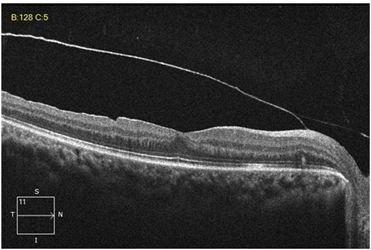

Complete Resolution of SubHyaloid Hemorrhage with Nd: YAG Hyaloidotomy: A Case Report
Ais Fricella 1![]()
,
Yasin Fadillah 1, Niken
Indah Noerdiyani 2
1 Department
of Vitreoretinal Ophthalmology, Rumah Sakit Mata Masyarakat Jawa Timur,
Surabaya, Indonesia
2 Department
of Pediatric Ophthalmology, Rumah Sakit Mata Masyarakat Jawa Timur, Surabaya, Indonesia
|
|
ABSTRACT |
||
|
Background: Subhyaloid hemorrhage is a vision-threatening condition commonly caused by retinal vascular disorders, trauma, or systemic diseases such as hypertension and diabetes mellitus. Management strategies vary, ranging from observation to surgical interventions. Nd: YAG laser hyaloidotomy has emerged as a minimally invasive therapeutic option that allows for rapid drainage of premacular blood into the vitreous cavity, thus accelerating visual recovery. Case Presentation: We report the case of a 17-year-old girl who experienced acute, painless vision loss in her right eye after a Valsalva maneuver. Fundus examination revealed a dense, boat-shaped premacular hemorrhage consistent with subhyaloid hemorrhage. Nd: YAG laser hyaloidotomy was performed using a posterior capsulotomy lens and a single 3.5 mJ pulse to puncture the posterior hyaloid face. Immediate drainage of blood into the vitreous cavity was observed. Over a follow-up period of eight weeks, complete resolution of hemorrhage and significant improvement of visual acuity (from counting fingers at 4/60 to 6/6) were documented. Conclusion: Nd: YAG hyaloidotomy represents an
effective, safe, and minimally invasive therapeutic approach for selected
cases of subhyaloid hemorrhage. This case
underscores the importance of timely intervention in preventing prolonged
visual impairment and highlights the role of laser therapy as an alternative
to invasive vitreoretinal surgery. |
|||
|
Received 07 August 2025 Accepted 08 September 2025 Published 04 November 2025 Corresponding Author Ais
Fricella, aisfricella@gmail.com DOI 10.29121/granthaalayah.v13.i10.2025.6369 Funding: This research
received no specific grant from any funding agency in the public, commercial,
or not-for-profit sectors. Copyright: © 2025 The
Author(s). This work is licensed under a Creative Commons
Attribution 4.0 International License. With the
license CC-BY, authors retain the copyright, allowing anyone to download,
reuse, re-print, modify, distribute, and/or copy their contribution. The work
must be properly attributed to its author.
|
|||
|
Keywords: Subhyaloid Hemorrhage,
Nd: YAG Hyaloidotomy, Premacular
Hemorrhage, Vitreous Hemorrhage, Retinal Laser Therapy |
|||
1. INTRODUCTION
Subhyaloid hemorrhage is an ophthalmological condition characterized by the accumulation of blood between the internal limiting membrane (ILM) and the posterior hyaloid. The clinical manifestation is usually a sudden decrease in visual acuity, especially when bleeding covers the fovea.[1] Classically, the funduscopic image shows a "boat-shaped hemorrhage" with a clear horizontal upper border due to gravity. This condition can be caused by various factors, including proliferative diabetic retinopathy, retinal vein occlusion, trauma, and Valsalva phenomenon (Valsalva retinopathy).[2]
Historically, therapeutic options for subhyaloid hemorrhage have varied widely. In minor cases or those that do not disturb the fovea, observation can be carried out because the blood can undergo spontaneous resorption within a few weeks to months. However, prolonged resorption can cause complications such as hemoglobin toxicity to the retina, proliferation of the epiretinal membrane, or the formation of subfoveal scar tissue, which results in permanent visual impairment.[3]
As technology develops, Nd: YAG laser therapy is becoming an attractive alternative. This technique was first introduced by Gabel et al. in 1989 as a method for performing "hyaloidotomy" or "membranotomy" in cases of premacular hemorrhage.[4]
Compared with pars plana vitrectomy, Nd: YAG hyaloidotomy offers several advantages, including: (1) minimally invasive: does not require intraocular surgery; (2) fast and effective: allows visual improvement within days to weeks; and (3) lower costs and less risk of complications compared with surgical procedures.[5] However, this procedure is not free from risks. Potential complications include re-bleeding, retinal damage due to excessive laser energy, or incomplete drainage if the perforation is too small or in the wrong location.[6]
In this context, case reports are important to document the success of Nd: YAG hyaloidotomy therapy in patients with subhyaloid hemorrhage. In addition, publications such as this provide additional evidence to strengthen the position of laser therapy as the modality of choice in selected cases, especially in health care centers with limited vitreoretinal surgical facilities.
This report presents a case of subhyaloid hemorrhage due to the Valsalva phenomenon that was successfully treated with Nd: YAG hyaloidotomy. Through clinical, procedural descriptions and final results, it is hoped that this article can contribute to medical literature as well as become a clinical reference for ophthalmologists in the field.
2. Case Report
A 17-year-old girl came to the emergency room at RS Mata Masyarakat Surabaya complaining of sudden painless loss of vision in her right eye for 6 days after weightlifting. The patient had no pain, photophobia, or floaters. The history of trauma and chronic illness was denied. The patient also has no history of diabetes mellitus or hypertension. There was no history of anticoagulant use or other systemic diseases.
On examination, her visual acuity was reduced to 4/60 OD and 6/6 OS. The intraocular pressure was normal in both eyes. All blood tests, including CBC and coagulation tests, were within normal range. Fundus photography demonstrated a subhyaloid haemorrhage with a dome-shaped shaped. OCT imaging of the right eye reveals a hyperreflective accumulation over the macular region.
This patient was diagnosed with subhyaloid hemorrhage OS associated with valsal retinopathy (Valsalva retinopathy).
The patient was decided to undergo Nd: YAG hyaloidotomy after being explained the procedure, benefits, and risks. Informed consent was obtained: First, the procedure: performed with slit-lamp biomicroscopy using a fundus lens (posterior capsulotomy lens). Second, laser settings: initial energy 2.5 mJ, increased to 3.5 mJ. Third, target: the inferior part of the hemorrhage, in the non-foveal area, to reduce the risk of macular damage. Fourth, the results of the procedure: with one shot, a small perforation was formed in the posterior hyaloid membrane. Blood flow to the vitreous cavity is visible immediately after the laser is applied.
Patients were observed for 1 hour after the procedure.
There were no immediate complications such as increased intraocular pressure or
rebleeding.
Follow-up of the treatment carried out is: First, week 1: OS visual acuity increases to 6/7.5. The fundus shows that blood has largely moved to the vitreous cavity, with the macula beginning to open. Second, Week 2: visus OS 6/7.5. Residual vitreous hemorrhage is visible but progressively diminishing. OCT showed improved macular reflectivity. Third, Week 4: OS vision reaches 6/6. The vitreous hemorrhage disappeared completely, and there was no sign of epiretinal membrane or macular edema.
This paper is a single case report documenting the treatment of subhyaloid bleeding with Nd: YAG hyaloidotomy in a patient diagnosed with Valsalva retinopathy. Writing follows the CARE Guidelines standards for reporting clinical cases.
The diagnosis is made based on anamnesis, visual examination, fundoscopy, and OCT. Basic laboratory tests were performed to rule out coagulopathy.
In the Nd: YAG Hyaloidotomy treatment, it is given by following standard operating procedures: first, preparation: the patient is given topical anesthetic drops (proparacaine 0.5%) and mydriatics (tropicamide 0.5%). Second, Instruments: slit-lamp biomicroscope with Nd: YAG laser (1064 nm) and posterior capsulotomy fundus lens. Third, technique: the shot target is selected at the inferior part of the bleeding, around 1 DD (disk diameter) from the fovea. Fourth, Energy: starting with 2.5 mJ, increased to 3.5 mJ. One shot is enough to create a perforation. Fifth, Observation: immediately after the laser, blood flow can be seen entering the vitreous, characterized by a reduction in the density of subhyaloid hemorrhage.
Next, patients were evaluated serially with visual examination, fundoscopy, OCT, and intraocular pressure at the 1st, 2nd, and 4th weeks post-procedure.
The patient provided written informed consent for the procedure and publication of this case report. The patient's identity is kept confidential in accordance with the code of medical ethics and the principles of the Declaration of Helsinki.
The patient was treated with Nd: YAG hyaloidotomy. Follow-up examination of her right eye after one month showed complete resolution with visual acuity 6/6.
3. Results
A 17-year-old female patient with subhyaloid hemorrhage due to Valsalva retinopathy underwent an Nd: YAG hyaloidotomy procedure with one shot of 3.5 mJ energy. The procedure went smoothly without intraoperative complications.
From the treatment given, clinical results can be presented: First, immediately after the procedure, blood appears to flow from the subhyaloid space to the vitreous cavity. Partial transparency of the macula begins to emerge. Second, control 1 day after treatment: visual acuity increased from 4/60 to 6/7.5 (vision reached 6/7.5). The fundus showed resolution of most of the premacular hemorrhage, with moderate vitreous hemorrhage. The fundus showed progressive vitreous clearance. OCT showed a recovering foveal contour, with no signs of structural damage. Third, 4 weeks (1 month) control: visual acuity improves to 6/6.
No serious side effects were found in this treatment. Intraocular pressure was stable (14–16 mmHg throughout follow-up). There was no rebleeding. There were no complications such as epiretinal membrane, cystic macular edema, or retinal detachment.
The outcome showed that the patient achieved complete resolution of subhyaloid hemorrhage and significant visual improvement from 4/60 to 6/6 within 4 weeks.
Table 1
|
Table 1 Progression of Visual Acuity |
||
|
Follow-Up |
Visual Acuity |
|
|
OD (Injured Eye) |
OS |
|
|
Pre laser |
4/60 |
6/6 |
|
1 day after the laser |
6/7.5 |
6/6n |
|
1-month |
6/6 |
6/6 |
Figure 1

|
Figure 1 Wide-Field
Fundus Photo of the Patient’s Right Eye Revealed a Dome-Shaped Subhyaloidal Hemorrhage
Covering the Fovea. Figure 1 OCT Pre-Nd: YAG Hyaloidotomy. Between the Posterior Hyaloid Face and ILM,
Dome-Shaped, Over the Macula |
Figure 2

|
Figure 2 a. Fundus Photo Day 1
Post-Laser. Reveals Successful Drainage of Hemorrhage
Into the Vitreous Cavity, and Blood Is Seen Clearing
Away from the Fovea. Figure 2 Fundus Photo
1 Month Post-Laser. Confirms Complete Resolution of the Hemorrhage.
the Macula Is Clear, With A Thin White Laser Mark at the Previous Hemorrhage Site |
Figure 3
|
Figure 3 OCT Post Nd: YAG Laser After 1
Month |
4. Discussion
Subhyaloid hemorrhage is an accumulation of blood between the ILM and the posterior hyaloid membrane. The location of this hemorrhage causes a significant impact on visual function due to its position directly over the macula. Trapped blood can last a long time because of limited metabolic flow in that space. This poses a risk of iron toxicity, fibroglial proliferation, and permanent foveal damage if left untreated.[7]
This case shows how rapid intervention with Nd: YAG hyaloidotomy prevents long-term complications while speeding visual recovery.
Several approaches are available as management modalities to treat subhyaloid hemorrhage: First, observation: effective if the hemorrhage is small and does not cover the fovea. However, in cases of extensive bleeding, the resorption time can be months with the risk of permanent retinal damage.[8] Second, pars plana vitrectomy: an invasive procedure that effectively removes blood and hyaloid membranes. However, the risk of complications is higher (cataract, retinal detachment, endophthalmitis), and the costs are greater.[9] Third, intravitreal injection of tPA + gas: used especially when accompanied by subretinal bleeding. But it requires a special patient position (prone position), and the risk of complications remains.[10] Fourth, Nd: YAG laser hyaloidotomy: a non-invasive, fast, effective procedure, with a relatively low risk of complications. Suitable for cases with acute, extensive bleeding and covering the macula.[11]
This case supports the literature evidence that Nd: YAG hyaloidotomy is an effective therapeutic option for subhyaloid hemorrhage due to Valsalva retinopathy.
Some literature related to the technique of optimizing Nd: YAG Hyaloidotomy states that the success of the procedure is very dependent on several technical factors: First, the target location: the inferior part of the bleeding, far from the fovea and large blood vessels. Second, laser energy: generally, 2–5 mJ. Energy that is too low does not penetrate the membrane, and too high a risk damages the retina.[12] Third, number of shots: minimum possible, ideally one. Multiple shots increase the risk of retinal perforation.
In this case, a single shot of 3.5 mJ was sufficient to produce effective perforation. Blood drainage occurs immediately, thereby speeding up visual recovery.
In this case, a single shot of 3.5 mJ was sufficient to produce effective perforation. Blood drainage occurs immediately, thereby speeding up visual recovery.
These results are in accordance with previous case reports. First, Meyer et al. (2005): reported rapid resolution of subhyaloid hemorrhage with Nd: YAG hyaloidotomy, with significant visual improvement in 2–8 weeks.[13] Second, Gabel et al. (1989): pioneers of this technique, reporting success in patients with acute premacular hemorrhage without serious complications.[14] Third, Ulbig et al. (1998): showed good long-term results, although some patients experienced minor rebleeding that resolved spontaneously.[15]
Thus, the results in this patient are consistent with the literature, namely complete resolution in 4 weeks with recovery of near-normal vision.
Even though it is safe, Nd: YAG hyaloidotomy still has potential complications, including: (1) re-bleeding due to laser trauma to the blood vessels; (2) Retinal damage, if the shot is too close to the fovea; (3) Epiretinal membrane, due to proliferation of glial cells after bleeding.[16]
In this case, none of the complications occurred, indicating that appropriate patient selection and procedural technique are key determinants of success.
Significance of the Case
This case has several important points. First, Nd: YAG hyaloidotomy is an effective treatment for acute subhyaloid hemorrhage. Second, vision can recover optimally if intervention is carried out early. Third, the procedure is relatively safe, with minimal risk of complications if the technique is carried out correctly. Thus, this case strengthens the position of Nd: YAG hyaloidotomy as the first alternative in cases of extensive premacular hemorrhage, especially in facilities without vitrectomy access.
5. Conclusion
Nd: YAG hyaloidotomy is an effective, safe, and minimally invasive therapeutic modality for treating subhyaloid bleeding covering the macula. This procedure can speed up blood resolution, restore vision, and prevent long-term retinal damage. This case report strengthens the literature evidence that Nd: YAG hyaloidotomy is a valuable alternative for patients with premacular subhyaloid hemorrhage.
CONFLICT OF INTERESTS
None.
ACKNOWLEDGMENTS
None.
REFERENCES
Charles, S. (2012). Vitreous Microsurgery
(4th ed.). Wolters Kluwer.
Duane, T. D. (1972). Valsalva Hemorrhagic Retinopathy.
Transactions of the American Ophthalmological
Society, 70, 298–313.
Figueroa, M. S., Contreras, I., & Noval, S. (1998). Laser Treatment for Preretinal Subhyaloid Hemorrhage. European Journal of Ophthalmology, 8(3), 169–172.
Gabel, V. P., Birngruber, R., Gunther-Koszka, H., & Puliafito, C. A. (1989). Nd:YAG Laser Membranotomy for Preretinal Hemorrhage Under the Internal Limiting Membrane. American Journal of Ophthalmology, 108(1), 85–89. https://doi.org/10.1016/0002-9394(89)90811-8
Gabel, V. P., Birngruber, R., Gunther-Koszka, H., & Puliafito, C. A. (1989). Nd:YAG Laser Photodisruption of Hemorrhagic Detachment of the Internal Limiting Membrane. American Journal of Ophthalmology, 107(1), 33–37. https://doi.org/10.1016/0002-9394(89)90811-8
Glatt, H., & Machemer, R. (1982). Experimental Subretinal Hemorrhage in Rabbits. American Journal of Ophthalmology, 94(6), 762–773. https://doi.org/10.1016/0002-9394(82)90301-4
Hernández-Emanuelli, M. E., Echegaray, J. J., & Emanuelli. (2024). Nd:YAG Laser Hyaloidotomy: A Therapeutic Approach for Valsalva Premacular Hemorrhage. Cureus, 16(3), e56872. https://doi.org/10.7759/cureus.56872
Kapoor, A., & Bansal, R. (2013). Nd:YAG Laser Hyaloidotomy
for Premacular Hemorrhage: Factors Determining
Visual Outcome. Indian
Journal of Ophthalmology, 61(2), 65–68.
Kuhn, F., & Morris, R. (1998). Withstanding The Test of Time:
Spontaneous Resolution of Premacular Hemorrhage. Ophthalmology, 105(2), 371–373.
Meyer, C. H., Mennel, S.,
Rodrigues, E. B., & Schmidt, J. C. (2005). Current Treatment Approaches for Preretinal Subhyaloid Hemorrhage. Graefe’s Archive for Clinical and
Experimental Ophthalmology,
243(9), 865–873.
Peyman, G. A., & Schulman, J. A. (1994). Intravitreal Surgery: Principles and
Practice. Mosby.
Poliner, L. S., & Tornambe, P. E. (1989). Vitreous Surgery for Premacular Hemorrhage. Ophthalmology, 96(4), 483–487.
Tripathi, A., Agarwal, R., & Chaurasia, S. (2022). Role of Neodymium Double Frequency Laser Posterior Hyaloidotomy in Delayed Presentation of Sub-Hyaloid Haemorrhage. Cureus, 14(1), e21534. https://doi.org/10.7759/cureus.21534
Ulbig, M. W., Mangouritsas, G., Rothbacher, H. H., Hamilton, A. M., & McHugh, J. D. (1998). Long-Term Results After Drainage of Premacular Subhyaloid Hemorrhage into the Vitreous with a Pulsed Nd:YAG laser. Archives of Ophthalmology, 116(11), 1465–1469. https://doi.org/10.1001/archopht.116.11.1465
Ulbig, M. W., Mangouritsas, G., Rothbacher, H. H., Hamilton, A. M., & McHugh, J. D. (1998). Long-term Results After Drainage of Premacular Subhyaloid Hemorrhage into the Vitreous with an Argon Laser. Archives of Ophthalmology, 116(11), 1465–1469. https://doi.org/10.1001/archopht.116.11.1465
[1] Hernández-Emanuelli
M. E., Echegaray J. J., Emanuelli. Nd: YAG Laser Hyaloidotomy: A Therapeutic
Approach for Valsalva Premacular Hemorrhage. 2024;16(3): e56872.
[2] Duane
TD. Valsalva hemorrhagic retinopathy. Trans Am Ophthalmol Soc.
1972;70:298–313
[3] Meyer
CH, Mennel S, Rodrigues EB, Schmidt JC. Current treatment approaches for
preretinal subhyaloid hemorrhage. Graefes Arch Clin Exp Ophthalmol.
2005;243(9):865–73
[4] Gabel
VP, Birngruber R, Gunther-Koszka H, Puliafito CA. Nd: YAG laser membranotomy
for preretinal hemorrhage under the internal limiting membrane. Am J
Ophthalmol. 1989;108(1):85–9
[5]
Tripathi A, Agarwal R, Chaurasia S. Role of Neodymium Double Frequency Laser
Posterior Hyaloidotomy in Delayed
Presentation of Sub-hyaloid Haemorrhage. 2022;14(1): e21534.
[6] Ulbig
MW, Mangouritsas G, Rothbacher HH, Hamilton AM, McHugh JD. Long-term results
after drainage of premacular subhyaloid hemorrhage into the vitreous with an
argon laser. Arch Ophthalmol. 1998;116(11):1465–9
[7] Charles
S. Vitreous microsurgery. 4th ed. Philadelphia: Wolters Kluwer; 2012
[8] Kuhn F,
Morris R. Withstanding the test of time: spontaneous resolution of premacular
hemorrhage. Ophthalmology. 1998; 105(2): 371–3
[9] Peyman
GA, Schulman JA. Intravitreal surgery: principles and practice. St.
Louis: Mosby; 1994
[10] Glatt
H, Machemer R. Experimental subretinal hemorrhage in rabbits. Am J
Ophthalmol. 1982; 94(6): 762–73
[11]
Figueroa MS, Contreras I, Noval S. Laser treatment for preretinal subhyaloid
hemorrhage. Eur J Ophthalmol. 1998;8(3):169–72
[12] Kapoor
A, Bansal R. Nd:YAG laser hyaloidotomy for premacular hemorrhage: factors
determining visual outcome. Indian J Ophthalmol. 2013;61(2):65–8
[13] Meyer
CH, Mennel S, Rodrigues EB, Schmidt JC. Incidence of Nd:YAG laser-induced
retinal complications after posterior capsulotomy. J Cataact Refract Surg.
2005;31(12):2329-2337
[14] Gabel
VP, Birngruber R, Gunther-Koszka H, Puliafito CA. Nd:YAG laser photodisruption
of hemorrhagic detachment of the internal limiting membrane. Am J Ophthalmol.
1989;107(1):33-37
[15] Ulbig
MW, Mangouritsas G, Rothbacher HH, Hamilton AM, McHugh JD. Long-term results
after drainage of premacular subhyaloid hemorrhage into the vitreous with a
pulsed Nd:YAG laser. Arch Ophthalmol. 1998;116(11):1465-1469
[16] Poliner
LS, Tornambe PE. Vitreous surgery for premacular hemorrhage. Ophthalmology.
1989;96(4):483–7
This work is licensed under a: Creative Commons Attribution 4.0 International License
© Granthaalayah 2014-2025. All Rights Reserved.